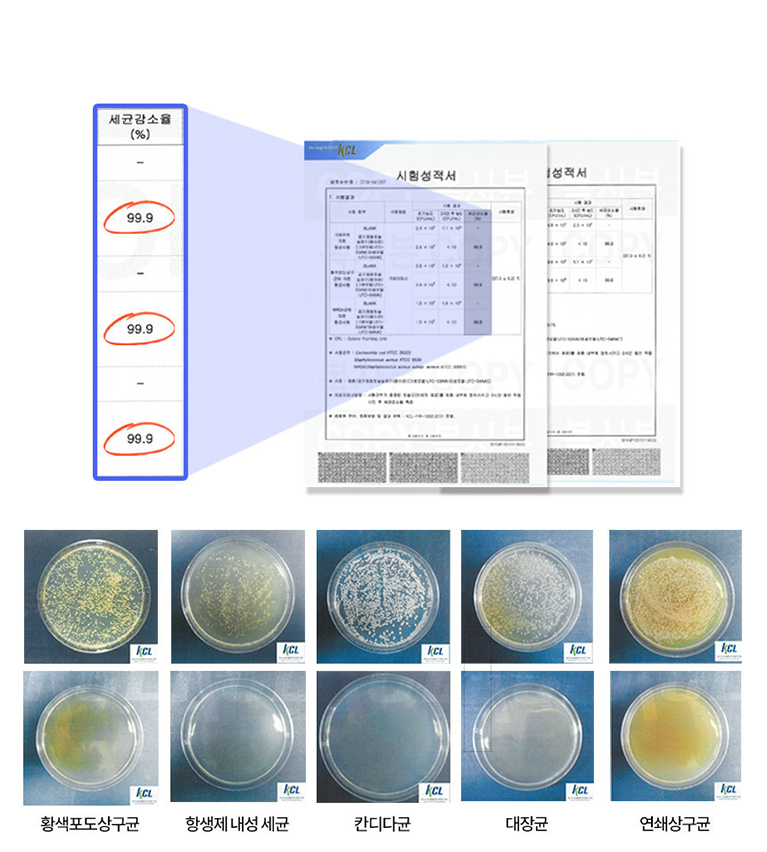

¿ÀÁ÷, ¾Û½ºÅ丮¸ôÀÌ¶ó¼ °¡´ÉÇÏ´Ù!
³õÄ¡¸é ÈÄȸÇϴ Ưº°ÇÑ ¼ºñ½º
º» »óǰÀÇ ´Üµ¶ ÇýÅÃÀ» È®ÀÎÇØº¸¼¼¿ä!
-
¿Â¶óÀÎ ÃÖÀú°¡ Á¦Ç°ÀÔ´Ï´Ù
Ÿ ¼îÇθôº¸´Ù ÆÇ¸Å±Ý¾×ÀÌ ºñ½Ò °æ¿ì, ±× Â÷¾×ÀÇ 2¹è ¸¶Àϸ®Áö·Î º¸»óÇØµå¸³´Ï´Ù.
-
¹è¼ÛÁö¿¬ º¸»ó Á¦Ç°ÀÔ´Ï´Ù.
¿¹»ó ¹è¼Û ¿Ï·áÀÏÀÌ Áö³ ÀÌÈÄ¿¡ »óǰÀ» ¹Þ¾ÒÀ» °æ¿ì, Áö¿¬ Àϼö¿¡ µû¶ó ¸¶Àϸ®Áö·Î º¸»óÇØµå¸³´Ï´Ù.
*ÁÖ¸», °øÈÞÀÏÀ» Á¦¿ÜÇÑ ¿µ¾÷ÀÏÀ» ±âÁØÀ¸·Î »êÁ¤ µµ¼»ê°£ Áö¿ª Á¦¿Ü
»ó¼¼Á¤º¸¸¦ È®´ëÇØ¼ º¼ ¼ö ÀÖ½À´Ï´Ù.
Á¦Ç° ±¸¸Å Àü ²À ÀоîÁÖ¼¼¿ä!
| ÀÎÁõÁ¤º¸ |
|
|---|---|
| Á¦Ç°Á¤º¸ |
|
| ¹è¼ÛÁ¤º¸ |
|
| Ãë¼Ò/ȯºÒ ¾È³» |
|